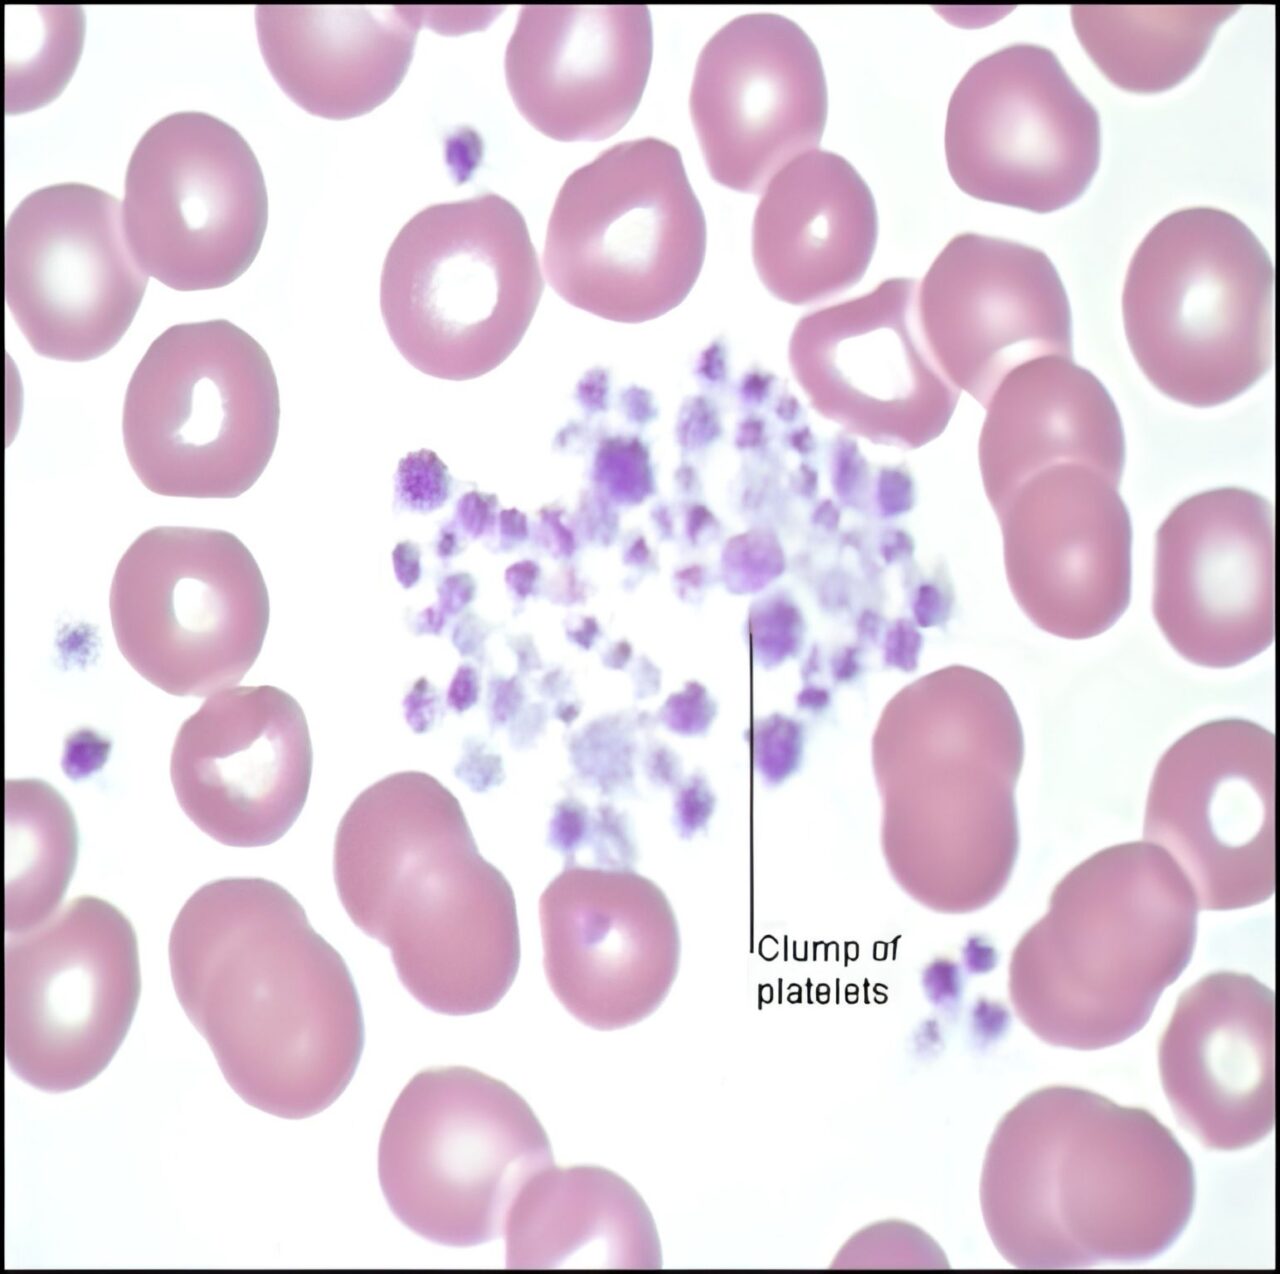

Photo: Depositphotos
Oct 21, 2025, 06:44
Asmaa A About Pseudo Thrombocytopenia: Causes and How to Handle
Asmaa A, DHA Medical Laboratory Technologis at Al-Ahrar International Hospital, shared a post on LinkedIn:
“Pseudo Thrombocytopenia — Causes & How to Handle
the analyzer shows low PLT even though the patient’s actual platelet count is normal.
This can mislead diagnosis unless recognized early.
The most common causes are five :
- Platelet Clumping (EDTA-dependent platelet agglutinins)
Common in EDTA samples — platelets stick together and appear fewer.
How to handle:
• Recollect in sodium citrate, multiply PLT & WBC ×1.1
• Or keep the EDTA sample at 37°C before analysis to prevent clumping - Platelet Satellitism
Platelets attach to WBCs, especially neutrophils (EDTA-related).
How to handle:Recollect in sodium citrate, multiply PLT & WBC ×1.1 - Rouleaux Formation
Seen in multiple myeloma, RBCs stack like coins → analyzer misreads counts.
How to handle: Wash with saline and rerun. - Giant Platelets
Large PLTs are counted as RBCs → falsely low PLT.
How to handle: Check peripheral blood smear (PBF) manually. - Clotted Sample
Due to poor mixing or delayed processing.
How to handle: Reject and recollect properly.
Always check the peripheral smear before reporting a low PLT count ,it could save you from a false report!”
Stay updated with Hemostasis Today.
-
Jan 10, 2026, 15:47Haematologica Journal Presents Review series on von Willebrand Disease
-
Jan 10, 2026, 15:15Stefan Gerner on Stroke Care and Subarachnoid Hemorrhage
-
Jan 10, 2026, 15:02Dr Manikanta Receives AHA Fellowship to Investigate Platelet-Dependent Nucleic Acid-Sensing Pathways
-
Jan 10, 2026, 14:40Last day at ASH25 from Riten Kumar
-
Jan 10, 2026, 08:56Shivanand Kumatagi Reflects on His Visit to Rela Hospital
-
Jan 10, 2026, 08:48Mitchell Elkind: Why Is The American Heart Association Holding a Brain Health Symposium?
-
Jan 10, 2026, 08:41Fiona Robinson Invites You to NBDF Webinar on Research Grants
-
Jan 10, 2026, 08:30Melissa Korn Takes Front Page Award for Her WSJ Piece on Experiencing a Pulmonary Embolism
-
Jan 10, 2026, 08:20Aymar Akilimali on Malaria in the Democratic Republic of Congo
